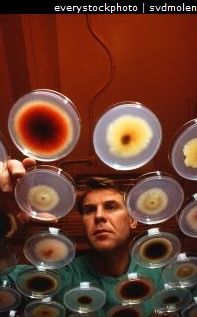
基因熵效应

作者:约翰▪圣弗德 (John Sanford)
正式译文开始之前:生物能否进化的根本问题在于基因层面能否发生进化——而基因熵问题的存在是对新达尔文主义机制在其根基上的否定。如此一来,就不是能否进化的问题了,
而是各类生物何时将因为其基因的不可逆转的逐渐瓦解而灭绝的问题了——进化论的火车,其实是往反方向开的。
下面的译文来自圣弗德(John Sanford)对其批评者的回复——由于不仔细阅读创造论科学家给出的证据(先入为主地认定创造论者一定是错的),或者偏面的使用证据,以及缺乏学术批判性思维地采纳进化论者的说辞、假设或推论,甚至采取把问题个人化、感情化乃至人身攻击、戴帽子等,都是盲目批评者些常见的现象——因此这里译者所选择的是圣弗德教授对某位典型的批评者对他和他团队有关基因熵研究的批评的回复,个人认为具有普遍意义。
原文网址:http://creation.com/genetic-entropy

对《基因熵》罔顾事实的批评
作者在基因组衰退问题上写下里程碑意义的专著,他对无根据的批评进行回应
我通常不会花时间去回复博客,但有些人要求我回应斯科特?布堪南(Scott Buchanan)针对本人的专著《基因熵》(genetic entropy, 中文第一版书名为《退化论》)的批判 1。由于我花不起时间耗在网络博客里或因此被无数邮件“杀死”,因此这将是一次性的回复与澄清。
斯科特冗长的文章绝不是出于客观的评价,而是基于先入为主的新达尔文主义信仰的、出于意识形态的攻击。他对我研究中所提出的对进化过程的合理质疑完全不予理会(可这些质疑中的很多看法甚至被我的同行遗传学家所普遍承认)。难道狂热的进化论者就不能诚实地承认现行进化理论中已知的问题吗?接下去我将简要地分析一下他的每一个论证。
斯科特以如下顺序给出他的观点:
1. 他首先声称我的书乃是故意欺骗,且我在本质上是一个撒谎者(可或许我其实是一名诚实的基督徒)。
2.接着他花了三张页面表达他对我细致引用和参考木村相关研究的恼怒——而这里我是为了把突变效应的实际分布给阐释清楚。
3.他争论道,尽管有益突变是罕见的,可它们并不像我所表示的那般稀少。既然有益突变很明显地存在,且适应化也存在,于是他便想象 “基本假设”(即关于人类只不过是随机突变加自然选择的产物的假设)必定显然是正确的。
4.斯科特还列举了一系列充满漏洞的突变累计实验,他相信这些证明了有益突变的超高频率。
5.他指出基因复制可以导致实际的生物学效果。
6.他还指出,在长时期实验研究中,我们一般看不到可测量的衰退。他争辩说,如果我真的正确,则在最近的几千年里,所有短生命周期的生物(细菌、老鼠等)应该已经灭绝了。既然我们没有看到明显的基因衰退发生,则“基本假设”必定正确。
7. 斯科特提出,由于人类的寿命在最近几个世纪里增加了,这证明了人类的基因没有退化降解。
8.他辩论道,克劳(Crow)所做出的关于人类基因组目前正以每代1-2%的速率退化的结论 2,并不意味着克劳本人就不再相信“基本假设”。
9.他亦争辩道,协同上位效应(synergistic epistasis)3至少在某种程度上确实发生,并引用了认为协同上位效应有助于消除突变的一些人的观点。
10. 基于上述原因,他对于我书本附录中所引用的所有论文一概拒绝接受——可在这些论文里,来自群体遗传学领域的领军科学家都承认“基本假设”的所有根本性问题。
对我而言,斯科特的论证次序就错了。因为他先从无关紧要的议题开始,并且最后对最为关键的问题却企图轻描淡写蒙混过关。因此,接下来我将以和他相反的顺序一一答复他的论点。
10. 其它遗传学家怎么说
让我们先从我专著的最后部分(附录1)谈起,我在附录里引用的论文乃是群体遗传学领域中的旗帜人物的研究。斯科特说这是对无知读者的信息蒙骗的最高潮,可这种指责荒谬绝伦,因为我不过是引用了承认我书主要论点的该领域的领军人物。在这部分的前言中,我已经非常谨慎,没有暗示这些科学家可能认同我个人的观点。但我也指出,他们非常明确地全部承认我著作中所论述的关于“基本假设”的重大问题,即关于生物通过突变与自然选择而得以进化的主要问题!
该领域的这些专家为我著作的所有主要论点提供了强力支持……
a. 人类的基因现在依然在持续衰退吗?
![]() |
根据穆勒(Muller)、聂耳(Neal),、康桌寿(Kondrashov)、拿迟曼和克洛维尔(Nachman/Crowell)、沃克和凯特利(Walker/Keightley)、Crow(克劳)、林奇(Lynch)及其团队、豪威尔(Howell), 楼伟(Loewe)以及我本人(已付印)的相关论文,人类的基因确实在持续衰退。斯科特认为这个概念很愚蠢,并且否定克劳的论文(每代1-2%的基因降解率)。然而康桌寿,该领域的专家(进化论者),也向我建言道,几乎每一个他所认识的人类遗传学家都同意人类的基因正在发生降解和衰退。而最为明确的发现是2010年林奇在《美国国家科学院杂志》(PNAS)上发表的论文4,该论文认为人类的适合度每代下降3-5%。我个人认为突变对于适合度的平均效应比林奇的数字要小许多。因此,我认为人类衰败的速率比他所提出的要缓慢得多——但我们都认为人类的基因状况是在下降,而不是上升。难道斯科特还能找到坚持人类基因不在退化降解的够资格的遗传学家吗?人类基因现在是否正在降解衰败这个问题没有争论的余地。斯科特在这个问题上100%地错误,而且完全不了解相关研究。
b. 是否存在因无法选择的轻微有害的突变而造成的遗传负荷持续增加的问题?
根据穆勒、康桌寿、楼伟等许多人的说法,确实如此。群体遗传学家几乎全部承认,有相当一部分的有害突变由于效应微弱而无法被自然选择筛除。问题是,这些突变在全部突变中占多大比例?我研究这个问题已经有7年左右了。我和我团队的数值模拟显示,对于高等生物来说,有高达90%的有害突变无法被自然选择剔除(已付印)。而我已把手稿寄送斯科特,但看来他并没有阅读过。他能把这个理论问题解释掉吗?
c. 太田博士对于基因衰退有何看法?
太田朋子博士是木村的高足,曾与木村联名发表多篇论文。我们知道太田博士被誉为群体遗传学的皇后, 现今还是美国文理学院的名誉院士、美国国家科学院的外籍院士。她在近中性突变(near-neutral mutation)研究上是世界权威。我的一位联名作者飞去日本就我们的论文手稿与其讨论了几天。我们的数值模拟研究清楚地表明,近中性有害突变基本上无法被自然选择筛选,并且导致基因损害的持续线性累积。她承认我们的数值模拟看起来正确,我们的结论也似乎正确。这清楚地反应了一个深层的进化问题(而这也是康桌寿在其论文“何以人类没有灭绝100遍”中所陈述的矛盾5。)当她被问到关于协同上位效应(synergistic epistasis)的问题时,她即刻承认协同上位效应只会使进化论的困难更大,而不是缓解,正如我在书中所做的论证。我们的数值模拟已经确认了协同上位效应无法减缓突变累积,并且还会加速基因衰退(已付印)。我相信太田博士乐见我在这里澄清,她是一个忠实的达尔文主义者,依然相信“基本假设”,并且厌恶我的著作的主题。
d. 其他的引文:
我建议斯科特看看我在附录中的其它引述——很明显,群体遗传学的领军科学家长久以来已经承认,用突变与自然选择作为宏观进化的机制(即“基本假设”)存在重大理论问题——斯科特又为何要故意否定这些呢?
9. 协同上位效应
斯科特花了很多时间推销协同上位效应(Synergistic Epistasis)。他没有认识到的是,群体遗传学家几乎都知道,大多数的突变交互作用的方式要么是加法式的,要么是乘法式的。
如果有两个突变发生,且每个突变导致生物机体的适合度下降10%,则总体适合度或者下降20%(加法性交互作用),或者少于20%(乘法性交互作用),或者超过20%(协同上位效应)。协同上位效应如果发生的话,基因衰败显然会更快!一般地,进化论者求助于协同上位效应的唯一原因,是想论证多重基因损害会以某种方式促成更有效的选择。(现在我们能够清楚地显示,即便协同上位效应是常见的情况,这也会使得基因衰败的情况更糟)。而群体遗传学的理论基础,就是认定基因交互作用的主要方式是加法性或乘法性。假若协同上位效应是常态(其实它只是稀少的例外),那么迄今为止的群体遗传学领域的绝大多数论文都作废了!协同上位效应的情况首先必须是一个常态,才能去设想它可能会强化自然选择。
在自然情况下,我们知道所有可能的基因互动方式都发生在复杂的基因组里,包括协同上位效应。群体遗传学家通常很少考虑协同上位效应,但除了一件事——即拿来作为基因衰退现象的最后的救命稻草。但是仔细研究表明,即便协同上位效应是基因互动的主要方式而不是稀少的例外,这也只会让基因衰败的问题变得更为严重——这点我在书中已经指出了,而太田也得出了类似的结论。我们所做的大量数值模拟研究都表明了这一点(已付印)。
8. 克劳依旧相信进化论
斯科特又花了很多时间显示,尽管克劳本人相信人类正在以每代1-2%的幅度发生衰退,他还是信仰进化论的——这是肯定的,我在书中早就清楚地说过了。
7. 人类的平均寿命最近在增加
近几个世纪里确实如此,这是很显然的——但这可不是因为进化的原因,而是得益于改善了的饮食条件、卫生状况、以及现代医学。我们找到了避免婴儿死亡的方法,并延长了中年性疾病患者的预期寿命,因此平均寿命增加了。然而最长寿命可没有增加,这乃是很浅明的道理。 6
6. 基因熵效应在自然界里和实验室里并不明显
![]() |
大多数实验确实没有显示明显的衰败。然而斯科特必须认识到,(即便在年轻地球时间表里,)任何一个今天还存活的物种,其衰变必定是缓慢的,否则它们早就灭绝了。我在《基因熵》一书中给出的三个降解曲线都显示,当基因退化到一定程度时,其降解的速率会大大放缓。如果一类生物在今天依然活着,并且已经存在了数千年,其降解退化的速率必定极慢(在大多数情况中慢到无法测量)。因此基因衰败很显然不会在大多数实验室里清楚呈现。
至于斯科特论证所使用的病毒与细菌的问题,此类微生物的基因降解必定很慢,因为每个基因组的突变率低,加之选择不断发生且选择强度高。纵是这样的条件下,我们已经发表的论文,表明了RNA病毒明显
地表现出基因衰退7。另外一个使得病毒和细菌可以抵抗基因熵的原因是它们可以休眠数千年。这意味着即便活跃的菌株在一千年之后就灭绝,新的菌株也可以从自然休眠地不断被重新释放到环境中。
至于老鼠,我们的数值研究显示,老鼠之类的物种会比那些长寿哺乳动物更能够抵抗基因衰退的影响,从而使得其种群的寿命延长——因为它们每代的基因突变率低,而且它们受到选择筛选的周期更为频繁。因此,由于基因衰退而导致灭绝的动物,首先会是体型较大、寿命较长的动物。 8
即便假设物种并没有发生衰退,那么我们还是有一个物种维护的问题。仔细的分析研究显示,突变/自然选择不可能提供所需的维护。
5. 基因复制具有生物学效果
确实如此——但这和我们的研究有什么关系?如同在打字或学生论文中偶尔出现的重复——基本上全部是有害的,有益的极为罕见。但极少的有益复制完全无法抵消太多的有害复制的累积,更何况还有所有其他突变的蓄积。 9
4. 突变累积实验显示了极高的有益突变率
所谓的突变累积实验,对于理解有害突变的蓄积并没有多少帮助。因为这样的实验其实不是研究实际的突变,而仅仅是研究菌株的表现——所谓的“突变”只是推测。我检查过这一类的论文,没有发现其中有一例对实际突变的记录。所有的观察都是针对菌株的表现差异。至于表现型差异的原因,文章并没有排除非遗传因素,比如后生效应(epigenetic effect)或菌群中噬菌体病毒数目的增减。
更关键的是,由于绝对多数突变的效应极为微弱,并不导致明显的表现型,而这些实验只着眼于表现型上的重大改变,所以几乎所有的突变都是观察不到的。这样的实验只能观察到高影响性的突变,这是一种抽样偏差,不能代表实际突变谱。
而且,无论实验人员如何努力去排除自然选择,具有重大影响的有害突变在这样的试验中总会被剔除——因此,实验严重偏向于只观察到具有高度影响的有益突变。基音熵问题的核心是低度影响的有害突变,而这在此类试验中根本无法检测到这些突变。故而此类实验与我们对基因衰退的讨论实在是风马牛不相及。
最后一点,在这样的实验里,适合度的定义总是极其狭隘的(例如在给定的培养物中能生存)——对于简单的、单维的性征来说,任何影响这个性征的遗传变化都有可能是有益的(在单维的体系中,任何改变的效应只有上和下两个方向,可这与现实世界里生物性征的复杂网络大相径庭,现实世界里的适合度其实极其多维化)。
3. 有益突变究竟有多罕见?
按照斯科特的说法,我似乎不承认有益突变的存在,但我在中书公开承认有益突变是有的。然而我也坚持认为,包括我在内的几乎所有遗传学家都认同,有益突变相对于有害突变必定是极为罕见的。因此关键的问题乃是,究竟有多罕见?
基因组是生命赖以存在的遗传特质。特质显然有其内在的特异性。这意味着遗传特质的随机变化,其后果必然是信息破坏。这一点在ENCODE的结果发表之后已经变得特别清楚:我们的基因组中几乎没有垃圾DNA。10 ENCODE项目还揭示:大多数核苷酸参与多重的重叠编码——这就意味着,不在某种水平上带来有害效应的有益突变,少到不存在(我正在撰写一篇有关这个问题的论文)。而我们的数值模拟(出版过程中)表明,除非有益突变极多,否则它们不足以补偿有害突变的积累。
![]() |
这里的要点是,自然选择只能剔除最糟的有害突变,只能放大最强的有益突变。这意味着损害的累积很难观察到(好比汽车的锈蚀),而适应性的提高则很容易观察到(例如对抗生素的耐药性)。如此,即便斯科特给我们列举1000例通过有益的点突变(point mutation)而导致的适应性改变,他仍然没有触碰到最关键的问题——信息净增还是净减。适应性改变显示了相对于环境的基因微调,但不能解释生命内部惊人的工作机制,而对于解释基因组(起源)的奥秘还没有触及皮毛。
以人类为例,人类中哪里有有益的突变?而有害的突变有详实记录的就成千上万,以孟德尔遗传学的方式在人类的基因库中代代累积,尽管存在着针对这些突变的强大选择压力。然而这些容易观察到的有害突还只是冰山一角,绝大多数的有害突变根本不会导致清晰的表现型。可观察到的出生缺陷也有很高的频率,而且看上去全部是有害的——且再一次,这依旧只是冰山一角。那为什么没有观察到有益的先天性异常呢?这不是因为正面改变不容易识别。人类中假如确实有那么多有益突变发生,选择会非常有效地放大这些突变。有益突变应该处处涌现,应该比遗传病常见得多!可它们在哪里呢?欧洲成年人对乳糖的耐受能力可能是由于乳糖酶启动子被破坏;非洲一些人对于疟疾的抵抗力是由于血红蛋白的损坏;有20%的西欧人对于人类免疫缺陷病毒(HIV)抵抗力得益于一个趋化因子受体的破坏。有益突变会发生,但通常它们都是丧失功能的突变,即便如此,这些还是极为罕见。
斯科特又用林斯基(Lenski)的长期细菌实验大作文章,可这些结果其实反而支持我的论点。虽然出现了非常轻微的适应性改变(在给定的培养基上生长速度的优化),但是细菌的基因组却收缩了(功能性基因组减小了)。显然,生长加快主要是通过基因降解而实现的。许多原本有用的基因因为在那个环境中不需要而丢失了。一旦转移到天然环境中,那些高度退化的细菌会立即死亡。
看来斯科特觉得只要有益变化发生(无论它们多么稀少),“基本假设”就必定是正确的。同样,他相信只要发生了有选择的适应性变化(无论这些变化是多么地微不足道),这就证明了所谓的基因突变与自然选择真地可以是进化论的基石(即“基本假设”)。他似乎不明白,如果不经智慧设计,要产生基因组是多么地困难。他看来也不明白,即使选择过程能够放大一小簇有益突变,但由于大量轻微有害的突变,群体中仍然会发生基因衰败。他也没有意识到,一个物种虽然可以针对其生存环境做出适应性的精细调整,但在很多其他方面仍然在退化。
让我把话说得更明白些,比如一部开了十年的汽车,它的方方面面都在退化。给它装上新的雨刷,难道这部汽车就会停止退化了吗?这的确是个改善,但这种改善不能逆转无处不在的、系统性的崩坏。
通过与其他的科学家的合作,我们在对于突变/选择过程的数值模拟方面开发出最先进的软件——“孟德尔的会计师”(Mendel's Accountant),推进了群体遗传学领域的发展。11 如果使用符合生物学现实的参数,该软件无一例外地显示基因衰败。即便将有益突变率设置得很高,该软件显示基因衰退还是会发生。这有力地验证了我的著作。“孟德尔的会计师”虽然不能告诉我们生命的真实历史,但它能告诉我们,在今天的现实世界里,自然选择能够做到什么,不能做到什么。
2. 木村的数据
![]() |
我在书中引用了的木村论文中的一张图,斯科特对此又颇多微词。他声称我曲解了木村,其实是他曲解了我(我并没有声称木村同意我的观点)。但这是转移焦点的做法,我要论证的核心不是木村,而是要确定突变效应的正确分布。就有害突变而言,木村和大多数群体遗传学家同意,突变效应基本上呈指数分布。我书中的图3c(基于木村的工作)描绘了有害突变的指数型分布。大多数的有害突变是“近中性的”,因此无法选择(实际中性)。但正如我所指出的,木村的图示并不完整,因为退化的核心是有益突变和有害突变的比例。木村并没有显示有益突变的分布,但这对于信息净增还是净减的问题至关重要。当我画出了有益突变的分布后(我相信如果要木村画的话,他画出的应该和我的差不多),任何人都可以看到问题的所在——大多数的有益突变是不可选择的(图 3d)。斯科特并没有反对我关于突变效应分布的描述——而这才是主要问题。斯科特应该很容易看出,大多数的突变都处在“非选择”区内,而且几乎全部是有害的。因此,即便在强力选择下,“非选择区”内的一切改变都只能导致退化。而在这个区间之外,明显的有害突变会被剔除,而偶尔发生的罕见的高影响力有益突变会被放大(这可以解释一些个别事例,如抗生素耐药性)。
1. 圣弗德是一个骗子
斯科特一遍又一遍地说我的专著全是故意撒谎,因此我本质上是一个骗子。他给出的理由有二:其一是有一些文献他认为很重要,而我却没有引用,他便指责我隐藏和压抑证据。其二是他认为像我这样的人一定知道有益突变可以发生,自然选择也可以发生,而且长期实验没有显示迅速的基因退化——因此我就是故意不说出这些事,以欺骗无知读者。
他没有考虑到以下的可能性:
1. 有那么多的相关论文,没有引用几个太正常不过了;
2. 在哪些论文更重要这个问题上,我并不认同他的看法——因为他所列举的论文只谈到了最为表面的情况,如有益变化发生、选择发生、适应性改变——任何一个高中生都听说过这些——然而我和我团队的研究,正是在先承认了这些明显的事之后才做出的。
斯科特在网上发表这些话之前,我曾和他简短通信过——我已经试着向他解释,他的批评为何是不正确的,以及他为如何曲解了我,可我发现他不要听。后来我又寄给他一系列尚未出版的文稿——这些文稿深入而明确地答复了他的反对意见!现在再读他的文章,可以看出他压根没读我的稿件——那可都是些很严格的科研论文!我也可以从他目前的辩驳中,看出他也没有正经地去读我的书。如果斯科特既扭曲我的著作又扭曲了我的人格,那么在我和他之间,究竟谁有品德问题?
为了这本专著,我付出了很多,我基本上放下了我的名誉和学术生涯,就是为了要说出我所认为的真相。我确信真正最大的谎言乃是“基本假设”。我现在依然确信,我可以说服任何不怀偏见的人——只要这个人肯听:那套靠突变和选择能够导致进化的理论是站不住脚的。因此,我又为何要去撒谎呢?
我是一个真诚的正统基督徒,我相信上帝的确会审判我,我也认为撒谎乃是很严重的犯罪。我在我的研究领域有突出成就,珍视作为一个诚实科学家的名节。然而,对我而言,作为一名基督徒的纯全远比自己在科学界的地位更为重要。因此我愿意捍卫我所信仰的真理,尽管我知道攻击被奉为至圣的“基本假设”会遭到诽谤和嘲讽。我为何要写这样一本书,既毁掉了自己在科学界的良好声誉,又使我在上帝面前成为一个骗子?
我和斯科特通信一段时间之后,斯科特表示不会再回复了,并准备把我描述为一个故意撒谎的人。因此我对他最后的回复是,尽管我在某些论点上或许有技术上的错误,但我的书反映了我们所相信的真理。任何技术上可能出现的错误显示我不过是人,但书中肯定没有故意欺骗的成分。鉴于我们之前坦诚的交流,并且斯科特也自称是属耶稣的,我不认为他应该以这样的方式诽谤一位基督徒弟兄。我认为他应该道歉并收回这些人身攻击。至于科学上的争议,我要求他把我的回复作为附录贴到他的攻击性文章之后。
关于我的著作以及后续的研究在科学上的是非长短,我依然欢迎任何中肯和全面的分析。
切切
约翰∙圣弗德
【扩展阅读】
● 人类与黑猩猩的基因组几乎相同吗?--对有关文献的重新评估
参考文献
1. 批评性博客原文见letterstocreationists.wordpress.com/stan-4.
2. Crow, J., The high spontaneous mutation rate: Is it a health risk? Proceedings of the National Academy of Sciences94(16):8380–8386,1997; pnas.org/content/94/16/8380.full.
3. 协同上位效应是一种理论,认为多个突变的联合效应大于各个突变效应的总和。这对于有益突变显然是好事,但对有害突变是坏消息。见 Doyle, S., The diminishing returns of beneficial mutations, Journal of Creation 25(3):8–10, 2011.
4. Lynch, M., Rate, molecular spectrum, and consequences of human mutation, Proceedings of the National Academy of Sciences 107(3):961–968, 2010
5. Kondrashov, A., Contamination of the genome by very slightly deleterious mutations: why have we not died 100 times over? Journal of Theoretical Biology175(4):583–594, 1995.
6. Carter, R., Genetic entropy and human lifespans: If the human genome is degrading, shouldn’t lifespans be getting shorter? 15 July 2012.
7. Carter, R. and Sanford, J., A new look at an old virus: patterns of mutation accumulation in the human H1N1 influenza virus since 1918, Theoretical Biology and Medical Modelling 9(42):1–19, 2012.
8. Carter, R., Genetic entropy and simple organisms: If genetic entropy is true, why do bacteria still exist? 25 October 2012.
9. Liu, Y. and Moran, D., Do new functions arise by gene duplication? Journal of Creation20(2):82–89, 2006.
10. Williams, A., Astonishing DNA complexity uncovered, 20 June 2007, and Astonishing DNA complexity update, 3 July 2007.
11. Sanford, J. and Nelson, C., The Next Step in Understanding Population Dynamics: Comprehensive Numerical Simulation, Chapter 7 (pages 117–135) in: Carmen Fusté, M. (Ed.), Studies in Population Genetics, InTech, 2012.
原文见:国际创造论事工 www.creation.com